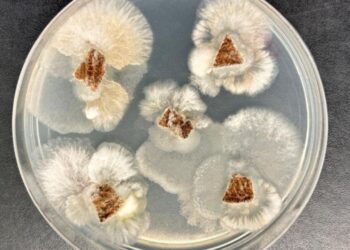
Molécula de fungo nativo supera glifosato em testes de laboratório

O aroma característico do café, presente no dia a dia de milhões de brasileiros, veio acompanhado de uma boa notícia em julho: o preço do grão moído registrou a primeira queda em um ano e meio. Dados divulgados pelo Instituto Brasileiro de Geografia e Estatística (IBGE) mostram que o recuo foi de 1,01% no último mês, interrompendo uma sequência de aumentos que, nos 18 meses anteriores, praticamente dobraram o valor do produto.
Apesar dessa trégua, o acumulado no ano ainda é expressivo: 41,46% de alta. Em 12 meses, o avanço chega a 70,51%, tornando o café moído o segundo item que mais impactou a inflação no período, com contribuição de 0,30 ponto percentual no Índice Nacional de Preços ao Consumidor Amplo (IPCA). Apenas as carnes, que subiram 23,34%, exerceram peso maior, respondendo por 0,54 ponto percentual.
Colheita amplia oferta e reduz preços
O IBGE atribui o recuo ao início da colheita, que aumentou a disponibilidade do produto no mercado. Com mais café circulando, a pressão causada pela demanda diminui e, consequentemente, os preços tendem a cair. Essa relação direta entre oferta e preço é um fenômeno típico do setor agrícola, especialmente em produtos de forte consumo interno, como o café.
Além disso, o impacto de tarifas de importação aplicadas pelos Estados Unidos — que desde 6 de agosto passaram a cobrar 50% sobre alguns produtos brasileiros, incluindo o café — ainda não aparece nos números de julho. Porém, especialistas apontam que, caso exportadores não encontrem novos compradores, o excesso de produto no mercado interno poderá ampliar a tendência de queda no curto prazo.